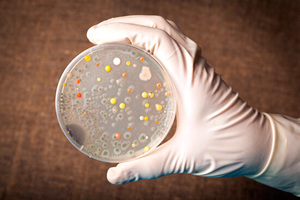
Анализ кала на ротавирус Диагностика ротавирусной инфекции

Ротовирусная кишечная инфекция — одна из основных причин диареи у детей до пяти лет. Эта статья поможет родителям и опекунам распознать симптомы, понять принципы лечения и профилактики, а также минимизировать риск повторного заражения. Знание этих аспектов важно для своевременного обращения за медицинской помощью и обеспечения здоровья ребенка, особенно в период сезонных вспышек инфекций.
Пути заражения ротавирусом
Кишечный грипп, который среди медиков называют «болезнью грязных рук», представляет собой инфекцию, передающуюся от человека к человеку. Заражение может произойти при непосредственном контакте с инфицированным или через использование его личных вещей. Кроме того, употребление загрязнённых продуктов также может стать причиной инфекции. Даже при строгом соблюдении гигиенических норм и создании комфортных условий жизни, полностью защититься от этого заболевания не всегда удается.
Когда ротавирус попадает в организм, он начинает активно размножаться в клетках слизистых оболочек и желудочно-кишечного тракта. Первые признаки болезни можно заметить по воспалению, чаще всего проявляющемуся в виде гастроэнтерита, что приводит к сбоям в работе пищеварительной системы. Возбудитель инфекции начинает покидать организм уже в первые дни после начала заболевания.
Врачи отмечают, что ротавирусная кишечная инфекция у детей проявляется яркими симптомами, такими как рвота, диарея, высокая температура и общая слабость. Эти признаки могут быстро привести к обезвоживанию, что особенно опасно для маленьких пациентов. Специалисты подчеркивают важность своевременной диагностики и лечения. Основным методом терапии является регидратация, которая помогает восстановить потерянные жидкости и электролиты. Врачами также рекомендуется соблюдать диету, исключая тяжелую и жирную пищу, и вводить в рацион легкие продукты. В некоторых случаях может потребоваться применение противовирусных препаратов. Профилактика, включая вакцинацию и соблюдение гигиенических норм, играет ключевую роль в снижении заболеваемости.
https://youtube.com/watch?v=H9gefPwOpEY
Симптомы ротавирусной инфекции у взрослых и детей
Инкубационный период ротавирусной инфекции обычно не превышает 5 дней. Заболевание начинается остро и, как правило, протекает в легкой форме. Первые признаки ротавирусной инфекции у детей включают:
- резкие схваткообразные боли в животе;
- рвоту, которая может возникать три-четыре раза в день;
- снижение аппетита;
- общее ухудшение состояния и слабость;
- повышение температуры тела до 39 градусов.
С течением времени у пациента появляется новый симптом — острая диарея. Стул становится водянистым, имеет желтоватый цвет, не содержит крови и выделяется с резким кислым запахом. На фоне интенсивной диареи может развиться острая дегидратация (обезвоживание), что представляет серьезную угрозу для жизни.
У взрослых определить критическую степень обезвоживания можно по спутанности сознания, его потере и судорогам.
Кроме того, врачи отмечают и другие клинические проявления, которые можно выявить при визуальном осмотре:
- покраснение конъюнктивы глаз;
- признаки гиперемии в области небных дужек и зева;
- на второй день после начала заболевания у пациента может развиться сонливость, что связано с ослаблением организма.
Симптомы, характерные для ротавирусной инфекции у взрослых, сохраняются примерно 4-7 дней, после чего наиболее выраженные признаки начинают ослабевать, и пациент выздоравливает, приобретая довольно устойчивый иммунитет к вирусу.
У взрослых часто наблюдается стертая симптоматика, проявляющаяся однократной диареей и незначительным кратковременным повышением температуры. Хотя это состояние не представляет серьезной угрозы для жизни, наличие даже легких клинических проявлений может сделать пациента разносчиком инфекции, что создает риск для окружающих.
| Симптом | Описание | Лечение |
|---|---|---|
| Рвота | Частая, многократная, обычно начинается внезапно. Может быть сильной и приводить к обезвоживанию. | Регидратация: Оральные регидратационные растворы (ОРС) маленькими порциями, часто. При сильной рвоте и невозможности пить – внутривенное введение жидкости в стационаре. |
| Диарея | Водянистый, частый, обильный стул, иногда с примесью слизи. Может продолжаться до 5-7 дней. | Регидратация: ОРС. Продолжение кормления грудью или адаптированной смесью. Диета: легкоусвояемая пища (рис, бананы, сухари). |
| Повышение температуры | Обычно умеренное (37.5-38.5°C), но может достигать высоких значений (до 39°C и выше). | Жаропонижающие средства: Парацетамол или ибупрофен в возрастной дозировке. Физические методы охлаждения (обтирания теплой водой). |
| Боль в животе | Спастические боли, колики, обычно умеренные. | Обезболивающие средства: При сильных болях – спазмолитики (по назначению врача). Тепло на живот (грелка). |
| Обезвоживание | Сухость слизистых оболочек, запавшие глаза, снижение тургора кожи, уменьшение мочеиспускания, вялость, плач без слез. | Немедленная регидратация: ОРС. При тяжелом обезвоживании – госпитализация и внутривенное введение жидкости. |
| Снижение аппетита | Отказ от еды, вялость. | Не форсировать кормление. Предлагать небольшие порции легкоусвояемой пищи. Главное – обеспечить достаточное питье. |
| Общая слабость, вялость | Ребенок становится апатичным, сонливым. | Покой. Обеспечение достаточного сна. |
| Профилактика | Вакцинация: Существуют вакцины против ротавируса, которые вводятся в раннем детстве. Гигиена: Тщательное мытье рук, особенно после туалета и перед едой. Изоляция больного ребенка. |
Ротовирусная кишечная инфекция: лечение у детей
При появлении первых признаков заболевания важно незамедлительно обратиться к врачу. Самостоятельное лечение в данной ситуации не только неэффективно, но и может представлять опасность.
Симптоматика ротавирусной инфекции часто схожа с проявлениями такой серьезной болезни, как холера. Ротавирусную инфекцию можно успешно лечить амбулаторно, тогда как некоторые кишечные инфекции требуют немедленной госпитализации для оказания медицинской помощи.
На сегодняшний день ученым не удалось разработать специфические методы лечения ротавируса. Поэтому в аптечных сетях отсутствуют противовирусные препараты, которые могли бы целенаправленно воздействовать на этот возбудитель.
https://youtube.com/watch?v=sC_1Km2bbXs
Лечебные мероприятия
Если у человека диагностирован ротавирусный гастроэнтерит, ему назначают лечение, направленное на облегчение симптомов. Основным мероприятием в процессе терапии является регидратация. При правильном выполнении этого процесса можно устранить обезвоживание, вызванное диареей и рвотой. Чтобы избежать дегидратации и восстановить водно-электролитный баланс, специалисты рекомендуют использовать раствор препарата Регидрон.
Для его приготовления нужно взять один пакетик лекарства и развести его содержимое в одном литре воды. Малыш должен принимать этот раствор по 50 мл каждый час. Употреблять средство в больших объемах не следует, так как это может привести к рвоте, что затруднит эффективное лечение.
Если в вашей аптечке нет готовых препаратов, вы можете самостоятельно приготовить раствор для гидратации. Для этого потребуется литр кипяченой воды, в которую добавляют 1 чайную ложку пищевой соды, поваренной соли и 2-4 столовые ложки сахара. Ребенок должен принимать этот раствор до восстановления нормального диуреза, оптимально — не реже одного раза каждые 3 часа.
При диагностировании ротавирусной инфекции детям назначают щадящую диету. Сразу при появлении первых симптомов следует исключить молоко и молочные продукты, так как в условиях болезни усвоение лактозы значительно ухудшается. Однако это правило не касается грудных детей. Новорожденные могут получать грудное молоко один-два раза в сутки в течение двух-трех недель, а в остальные дни им дают соевую или безлактозную смесь.
В остром периоде у ребенка может полностью пропасть аппетит, поэтому не стоит заставлять его есть. В начале заболевания полезно предложить малышу легкие блюда — жидкие каши на воде, куриный бульон или домашний кисель.
При подтвержденном диагнозе ротавируса детям могут назначить спазмолитик Но-шпа для облегчения спастических болей в животе, который следует принимать перорально в дозировке 1 мл.
Если диагностика выявила гипертермию, детям старше 1,5 лет можно давать 1/4 таблетки анальгина и 1/2 таблетки парацетамола. Для нормализации температуры применяются ректальные суппозитории Цефекон, которые можно вводить каждые 2 часа при необходимости.
Важно помнить, что ротавирус погибает при температуре 38 градусов Цельсия. Поэтому снижать температуру у ребенка следует только тогда, когда она достигнет 39 градусов или выше. Эффективными средствами для лечения кишечных расстройств при ротавирусной инфекции являются Креон и Смекта.
На фоне воспаления слизистой кишечника и сильной диареи часто развивается дисбактериоз, который негативно сказывается на пищеварении и усвоении питательных веществ. Для нормализации микробиоценоза врач может назначить Бактисубтил в дозировке по одной капсуле дважды в день за час до еды. Перед применением препарат нужно растворить в воде.
При подтвержденном ротавирусном гастроэнтерите существует риск вторичной бактериальной инфекции. Чтобы предотвратить это осложнение, врачи рекомендуют использовать Энтероферол или его аналог Энтерол. Их принимают по одной чайной ложке дважды в день.
Если вы заметили, что ребенок часто хочет спать, дайте ему возможность отдохнуть столько, сколько ему нужно. Также регулярно измеряйте ему температуру и следите за тем, чтобы он пил часто, но небольшими порциями.
Ротавирусная инфекция у грудных детей
Для новорожденных детей дегидратация представляет собой серьезную угрозу, так как она может развиваться очень быстро. Наибольшему риску подвержены малыши с низким весом. При возникновении обезвоживания существует высокая вероятность потери сознания, а в некоторых случаях это может привести к трагическому исходу.
Определить критическую стадию дегидратации у новорожденных можно по следующим симптомам:
- сухость языка;
- плач без слез;
- снижение объема мочи;
- отсутствие потоотделения.
Важно помнить, что заставить ребенка пить из бутылочки может быть довольно сложно. Поэтому данный способ восполнения жидкости не является эффективным. Родителям грудных детей следует немедленно вызвать скорую помощь. Врачи проведут внутривенную регидратацию и, если это будет необходимо, направят ребенка и его маму в стационар для дальнейшего наблюдения.
Профилактика ротавируса
Для предотвращения повторного заражения ротавирусом применяется широко известный метод вакцинации. Однако стоит отметить, что он обеспечивает надежную защиту только в том случае, если вакцинация проводится детям в возрасте от 1,5 недель до 7-7,5 месяцев.
Тем, кто уже перенес инфекцию, рекомендуется временно избегать общения с другими людьми до полного выздоровления. Для ускорения процесса восстановления важно придерживаться простых правил личной гигиены, регулярно мыть руки горячей водой с мылом.
Анализы на ротавирус
Эффективность лечения ротавирусной инфекции во многом зависит от точности поставленного диагноза. Поэтому крайне важно провести дифференциальную диагностику, которая позволяет выявить:
- дизентерию;
- гастроинтерстициальные формы сальмонеллеза;
- балантидиаз;
- кишечный иерсиниоз;
- лямбиоз;
- эшерихиоз;
- холеру.
Для получения необходимой информации требуется анализ кала на ротавирус. Этот метод диагностики помогает исключить более серьезные заболевания.
О подтверждении диагноза ротавирусной инфекции можно говорить только в том случае, если в стуле пациента будет найден возбудитель. Для его выявления больным предлагается пройти антигенный тест.
После проведения этого теста лечащий врач принимает решение о наличии или отсутствии у пациента устойчивости к ротавирусу. Если у пациента нет никаких отклонений в состоянии здоровья, тест должен показать отрицательный результат.
Заключение
Ротавирусная инфекция представляет собой серьезную угрозу для здоровья детей. Если лечение не начато вовремя, это может привести к серьезным осложнениям. Поэтому крайне важно знать, каковы первые симптомы этого заболевания. При их появлении необходимо незамедлительно обратиться к врачу для диагностики.
Каждый случай заражения ротавирусом, как у взрослых, так и у детей, имеет свои особенности. Для того чтобы подобрать наиболее эффективное лечение, врачу необходимо собрать как можно больше информации о пациенте и его состоянии. Самостоятельное лечение этого опасного заболевания строго не рекомендуется. Попытки справиться с недугом без профессиональной помощи могут привести к потере времени и усугублению ситуации, что в итоге может вызвать более тяжелую форму болезни.
https://youtube.com/watch?v=WsqASK-1ylw
Осложнения ротавирусной инфекции
Ротавирусная инфекция, как правило, протекает в легкой или средней форме, однако в некоторых случаях может привести к серьезным осложнениям, особенно у детей младшего возраста. Одним из наиболее распространенных осложнений является обезвоживание, которое возникает в результате интенсивной диареи и рвоты. Обезвоживание может быть опасным для жизни, если не будет своевременно выявлено и устранено. Симптомы обезвоживания включают сухость во рту, уменьшение количества мочи, вялость, повышенную жажду и, в тяжелых случаях, спутанность сознания.
Другим возможным осложнением является развитие вторичной бактериальной инфекции. При ослаблении иммунной системы, вызванном ротавирусом, организм становится более уязвимым к другим инфекциям, что может привести к пневмонии или отиту. Важно следить за состоянием ребенка и при появлении новых симптомов обращаться к врачу.
Также стоит отметить, что у некоторых детей может развиться синдром раздраженного кишечника после перенесенной ротавирусной инфекции. Это состояние характеризуется хроническими болями в животе, изменениями в стуле и дискомфортом. Хотя синдром раздраженного кишечника не является непосредственным осложнением ротавируса, он может возникнуть как следствие нарушения работы кишечника после инфекции.
В редких случаях ротавирусная инфекция может привести к более серьезным состояниям, таким как острый гастроэнтерит, который требует госпитализации и интенсивного лечения. При этом важно помнить, что ранняя диагностика и адекватное лечение могут значительно снизить риск развития осложнений.
В связи с вышеизложенным, родителям следует быть особенно внимательными к состоянию своих детей в период болезни. При появлении признаков обезвоживания или других настораживающих симптомов необходимо незамедлительно обратиться за медицинской помощью. Профилактика ротавирусной инфекции, включая вакцинацию и соблюдение правил гигиены, также играет ключевую роль в снижении риска осложнений.
Роль вакцинации в профилактике ротавирусной инфекции
Вакцинация является одним из наиболее эффективных способов профилактики ротавирусной инфекции, особенно у детей младшего возраста, которые наиболее подвержены этому заболеванию. Ротавирусы являются основной причиной тяжелых гастроэнтеритов у детей, что может привести к серьезным осложнениям, таким как обезвоживание. Вакцинация помогает снизить риск заражения и тяжесть заболевания.
Существуют две основные вакцины против ротавирусной инфекции: ротатек и ротарикс. Обе вакцины являются живыми аттенуированными вакцинами и вводятся перорально. Вакцинация обычно начинается в возрасте 2 месяцев, с последующими дозами, которые вводятся в возрасте 4 и 6 месяцев. Важно соблюдать график вакцинации, чтобы обеспечить максимальную защиту.
Эффективность вакцин составляет около 85-98% в предотвращении тяжелых форм ротавирусной инфекции. Даже если вакцинированный ребенок все же заболевает, заболевание, как правило, протекает в более легкой форме, что снижает риск госпитализации и осложнений.
Вакцинация не только защищает отдельных детей, но и способствует формированию коллективного иммунитета. Это особенно важно в условиях, когда в сообществе наблюдается высокая заболеваемость ротавирусной инфекцией. Чем больше детей будет вакцинировано, тем меньше вероятность распространения вируса.
Несмотря на высокую эффективность вакцинации, важно помнить, что она не заменяет другие меры профилактики, такие как соблюдение гигиенических норм, регулярное мытье рук и контроль за качеством пищи и воды. Вакцинация в сочетании с этими мерами обеспечивает наилучшую защиту от ротавирусной инфекции.
Родителям следует обсудить с педиатром вопросы вакцинации, чтобы получить полную информацию о возможных побочных эффектах и противопоказаниях. В большинстве случаев вакцина переносится хорошо, и риск серьезных побочных эффектов минимален.
Советы по уходу за детьми во время болезни
Во время болезни, вызванной ротовирусной инфекцией, важно обеспечить ребенку комфортные условия для восстановления и минимизировать риск осложнений. Вот несколько рекомендаций по уходу за детьми в этот период:
- Обеспечение покоя: Ребенок должен отдыхать, чтобы его организм мог сосредоточиться на борьбе с инфекцией. Убедитесь, что у него есть удобное место для сна и отдыха.
- Поддержание водного баланса: Одним из основных симптомов ротовирусной инфекции является диарея и рвота, что может привести к обезвоживанию. Важно предлагать ребенку пить много жидкости. Это могут быть специальные растворы для регидратации, которые можно приобрести в аптеке, а также чистая вода, компоты или разбавленные соки.
- Правильное питание: В период болезни лучше всего предлагать ребенку легкую, легко усваиваемую пищу. Это могут быть рис, картофель, бананы и яблочное пюре. Избегайте жирной, острой и тяжелой пищи, которая может усугубить состояние.
- Контроль температуры: Следите за температурой тела ребенка. Если она повышается, можно использовать жаропонижающие средства, рекомендованные врачом. Не забывайте, что высокая температура может быть нормальной реакцией организма на инфекцию, но при ее значительном повышении стоит обратиться к врачу.
- Гигиена: Обязательно соблюдайте правила личной гигиены. Мойте руки после каждого посещения туалета и перед кормлением ребенка. Это поможет предотвратить распространение инфекции в семье.
- Наблюдение за состоянием: Внимательно следите за состоянием ребенка. Если симптомы не улучшаются или ухудшаются, такие как высокая температура, сильная рвота или диарея, необходимо обратиться к врачу для получения профессиональной помощи.
- Психологическая поддержка: Не забывайте о психологическом состоянии ребенка. Заболевание может вызывать у него страх и беспокойство. Постарайтесь быть рядом, поддерживать его и объяснять, что происходит, чтобы он чувствовал себя в безопасности.
Следуя этим рекомендациям, вы сможете помочь своему ребенку легче перенести ротовирусную инфекцию и быстрее восстановиться после болезни. Однако всегда помните, что при возникновении любых сомнений или ухудшении состояния необходимо обратиться к врачу для получения квалифицированной помощи.